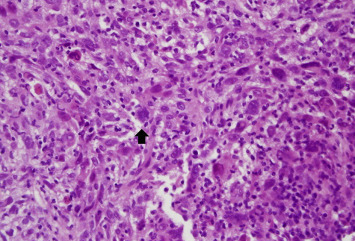
Hematoxylin and eosin staining of this liver tissue revealed some pleomorphic ...

Summary
Liver cystic neoplasms are uncommon and vary from benign to overtly malignant. Liver cystic metastases are rare and mostly come from colon, pancreas, ovary, kidney, neuroendocrine, and prostate cancer. Nasopharyngeal carcinoma (NPC) with liver cystic metastasis has only been reported once. Here, we report a 52-year-old man with liver cystic metastasis from locally cured NPC. The patient received concurrent chemoradiotherapy for NPC 4 years ago and presented with a 6-month history of upper abdominal fullness and pain. No evidence of local recurrence of NPC was found at his regular follow-up examinations after concurrent chemoradiotherapy. Abdominal magnetic resonance imaging showed a large, well-defined, lobulated cystic lesion with poor contrast enhancement occupying both lobes of the liver. Hepatic cystic metastasis was suspected. Ultrasound-guided liver tumor biopsy was performed. Histological examinations disclosed a pattern of poorly differentiated squamous cell carcinoma with focal sarcomatoid differentiation based on the P40 immunohistochemical stain. In situ hybridization for Epstein–Barr virus early RNAs confirmed the diagnosis of metastatic NPC. It is difficult to make a diagnosis in liver cystic neoplasms, especially from a rarely reported origin. In our case, we used clinical history and Epstein–Barr virus early RNAs as a specific marker to make an accurate diagnosis.
Keywords
Cystic metastasis; Epstein–Barr virus early RNA; Hepatic cystic neoplasm; Nasopharyngeal
Introduction
Nasopharyngeal carcinoma (NPC) is an epithelial cancer related to Epstein–Barr virus (EBV). NPC is endemic to certain well-defined populations. The highest incidence of NPC is found in a Cantonese region of Southern China. In Taiwan, there were 1579 new cases of NPC in 2007, and this condition ranked as the 10th most common cancer affecting the male population, with an annual incidence rate of 10.05 per 100,000 men [1]. NPC shows a rate as high as one-third for local or locoregional recurrence or metastasis. In various reports, the incidence of distant metastases from NPC ranges from 17% to 54%. Bone, lung, liver, and distant lymph nodes are the most common sites of distant metastases. Most liver metastases from NPC are solid, and cystic metastases are rarely reported [2].
Liver cystic lesions represent a heterogeneous group of disorders. Most liver cystic lesions tend to have a benign course. However, liver cystic neoplasms are rare and may vary from benign to overtly malignant [3]. The most commonly reported liver cystic neoplasm is cystadenoma. Other liver cystic neoplasms including primary neoplasms (cystadenocarcinoma and squamous cell carcinoma) or secondary from metastases (ovary, pancreas, and colon) are rarely reported. The origin of these liver cystic neoplasms may present a diagnostic challenge in daily practice. Here, we report a case of liver cystic metastatic neoplasms from NPC without evidence of local recurrence. EBV early RNAs (EBERs) are a valuable tool for accurate diagnosis of liver metastatic cystic neoplasms from NPC.
Case report
A 52-year-old man presented with abdominal fullness and pain and body weight loss of 5 kg in the past 6 months. He had a history of nonkeratinizing undifferentiated NPC, cT2aN2M0, Stage III and underwent concurrent chemoradiotherapy 4 years ago. There was no evidence of local recurrence in his recent regular follow-up examinations. He also had history of gastric ulcer bleeding and received subtotal gastrectomy 25 years ago. He had no known specific family history. He drank alcohol occasionally and was also a smoker for 25 years. Physical examinations revealed hepatomegaly (liver span of 15 cm in the right subclavian line and 9 cm in the sternum midline) with local tenderness over the epigastric region. Laboratory data showed anemia with hemoglobin 9.8 mg/dL (normal range: 13–17 mg/dL); normal serum total bilirubin 0.4 g/L (normal range: 0.5–1.5 g/L); normal aspartate aminotransferase 27 U/L (normal range: < 37 U/L); normal alanine aminotransferase 15 U/L (normal range: < 40 U/L); abnormal serum alkaline phosphatase 489 U/L (normal range: 40–129 U/L); abnormal r-glutamyl transpeptidase 302 U/L (normal range: 5–36 U/L); normal serum α-fetoprotein 2.05 ng/mL (normal range: < 5.0 ng/mL); normal carcinoembryonic antigen 2.83 ng/mL (normal range: < 5.0 ng/mL); abnormal serum carbohydrate antigen 19-9 53.4 ng/mL (normal range: 0–37 ng/mL); and abnormal anti-squamous cell carcinoma antigen 8.1 ng/mL (normal range: 0–2.1 ng/mL). Hepatitis B surface antigen and hepatitis C virus antibody were both negative. Blood EBV viral load was 82,801 copies/mL. Stool examination was normal. Abdominal plain film radiography disclosed no remarkable findings, except a nonspecific bowel gas pattern. Abdominal ultrasonography showed a lobulated cystic lesion about 20 cm × 16.5 cm × 17 cm, with mixed solid and cystic parts occupying occupying both lobes of the liver. Abdominal magnetic resonance imaging (MRI) showed a well-defined, lobulated cystic lesion with poor contrast enhancement occupying both lobes of the liver (Fig. 1). Nasopharyngoscopy performed by an ear, nose, and throat specialist demonstrated no local mass lesions. Only mild protruding on the central part of nasopharynx was noted and biopsies were taken. Esophagogastroduodenoscopy was performed to exclude malignancy of upper gastrointestinal origin. Only esophageal Candida colonization was found. For the definite diagnosis, biopsies from this cystic lesion were performed with the assistance of ultrasonography.
|
|
|
Figure 1. A large, well-defined, lobulated mixed cystic and solid lesion occupying both lobes of the liver showed hypointensity on T1-weighted imaging (A), hyperintensity on T2-weighted imaging (B), and diffusion-weighted imaging (C). During dynamic study, the lesion revealed poor contrast enhancement (D). |
Pathological examinations of nasopharyngeal biopsies showed only squamous hyperplasia with parakeratosis and focal moderate dysplasia without evidence of NPC recurrence. Histological examinations of the liver cystic neoplasm revealed some pleomorphic cells with a few spindle nuclei and frequent mitoses arranged in a solid nested pattern infiltrating the stroma (Fig. 2). Poorly differentiated squamous cell carcinoma with focal sarcomatoid differentiation was implied, based on the P40 immunohistochemical stain (Fig. 3). In addition to p40 immunohistochemical stain, in situ hybridization for EBERs was also positive ( Fig. 4). According to the past history and pathological evidence, metastatic NPC was confirmed. The patient underwent oral anticancer treatment with tegafur/uracil 100 mg/224 mg, two tablets twice daily, and was followed up at a regional medical institution. The size of the liver cystic metastatic lesion decreased after 3 months anti-cancer treatment.
|
|
|
Figure 2. Hematoxylin and eosin staining of this liver tissue revealed some pleomorphic tumor cells with occasional multinucleation (arrow; magnification 400×). |
|
|
|
Figure 3. p40 immunohistochemical stain revealed tumor cells of squamous epithelial origin (arrow; magnification 400×). |
Figure 4.
In situ hybridization of tumor cells revealed nuclear staining for Epstein–Barr virus early RNAs (arrow; magnification 400×).
Discussion
Liver cystic tumors may be solitary or multiple and can vary from benign to malignant and represent a diagnostic challenge in clinical practice. Cystic metastasis is the most important diagnosis to be excluded when multiple cystic lesions are observed in the liver. The cystic nature of some metastases is hypothesized to be secondary to rapid growth than the hepatic arterial supply of tumors, leading to central necrosis [4]. Hepatic metastases may originate from rapidly growing malignancy such as hypervascular tumors (sarcoma, melanoma, carcinoid, neuroendocrine tumors, and some lung and breast tumors) or from mucinous colonic or ovarian adenocarcinomas [5]. Colonic adenocarcinomas account for ∼50% of all multiple cystic liver metastases in adults [6]. Radiology may demonstrate the degree of liver involvement, multiplicity, border definitions, vessel displacement, and dynamic enhancement patterns [5]. Several studies have compared the diagnostic efficacy of MRI and computed tomography in patients with focal hepatic malignancies, and have demonstrated that MRI has better contrast resolution and can detect and characterize focal liver lesions with greater accuracy than computed tomography [7] and [8]. This is the reason why we chose abdominal MRI for further diagnostic assessment in the present case. However, it is difficult to make an accurate diagnosis simply from imaging. A clinical history of a known primary malignancy may help the diagnosis of liver cystic metastases, which can be confirmed by imaging-guided tissue biopsy and pathology.
NPC with liver metastasis usually presents with solitary or multiple solid tumors. Liver cystic metastatic lesions deriving from NPC have only been reported once [2]. Specific marker such as EBERs can be a useful tool for identification of the origin of metastatic NPC. EBV is associated with undifferentiated NPC. EBERs are often used as a marker to detect EBV-infected NPC cells [9]. Maohuai et al [10] demonstrated that in situ hybridization of EBERs in cytological smears had a role in the diagnosis of NPC, with a sensitivity of 92% and specificity of 100%. Chao et al [11] also demonstrated that EBERs can be used as a sensitive marker to identify NPC cells at various metastatic sites by in situ hybridization. That means that demonstration of EBERs in lesions of undifferentiated histology may be a useful diagnostic adjunct for NPC presenting as metastatic cancer of unknown origin [11]. Ho et al [12] demonstrated that all the primary lesions and the metastatic tumors of NPC with undifferentiated histology contained EBERs in the nuclei of cancer cells. EBERs can be detected in cells of the distant, relapsed metastatic sites, even when the primary tumor is cured. Therefore, EBERs can be useful to define the nature of a newly developed tumor in patients with a history of NPC. In our patient, EBERs were positive in the histology of liver cystic metastases, which confirmed that these metastases were from locally controlled NPC and helped to establish the final diagnosis.
Conflicts of interest
All authors declare no conflicts of interest.
References
- [1] Y.L. Lee, C.Y. Ho; Headache as the sole symptom of nasopharyngeal carcinoma and its clinical implications; Scientific World Journal (2012)
- [2] C.C. Kao, C.P. Yu, Y.C. Liu, J.C. Yu, C.B. Hsieh; Unusual presentation of cystic liver metastases from nasopharyngeal carcinoma; Onkologie, 31 (2008), pp. 635–636
- [3] P. Del Poggio, M. Buonocore; Cystic tumors of the liver: a practical approach; World J Gastroenterol, 14 (2008), pp. 3616–3620
- [4] K.J. Mortele, P.R. Ros; Cystic focal liver lesions in the adult: differential CT and MR imaging features; Radiographics, 21 (2001), pp. 895–910
- [5] B. Vachha, M.R. Sun, B. Siewert, R.L. Eisenberg; Cystic lesions of the liver; AJR Am J Roentgenol, 196 (2011), pp. W355–W366
- [6] M. Alobaidi, A. Shirkhoda; Malignant cystic and necrotic liver lesions: a pattern approach to discrimination; Curr Probl Diagn Radiol, 33 (2004), pp. 254–268
- [7] E. Senéterre, P. Taourel, Y. Bouvier, J. Pradel, B. Van Beers, J.P. Daures, et al.; Detection of hepatic metastases: ferumoxides-enhanced MR imaging versus unenhanced MR imaging and CT during arterial portography; Radiology, 200 (1996), pp. 785–792
- [8] M.B. Pitton, R. Kloeckner, S. Herber, G. Otto, K.F. Kreitner, C. Dueber; MRI versus 64-row MDCT for diagnosis of hepatocellular carcinoma; World J Gastroenterol, 15 (2009), pp. 6044–6051
- [9] C.B. Hsieh, C.J. Chen, J.C. Yu, T.M. Chang, H.W. Gao, Y.C. Liu; Primary squamous cell carcinoma of the liver arising from a complex liver cyst: report of a case; Surg Today, 35 (2005), pp. 328–331
- [10] C. Maohuai, A.R. Chang, L. Shikyuen; Roles of DNA cytometry and detection of EBERs in predicting a diagnosis of nasopharyngeal carcinoma; Anal Quant Cytol Histol, 23 (2001), pp. 207–212
- [11] T.Y. Chao, K.C. Chow, J.Y. Chang, C.C. Wang, T.Y. Tsao, H.J. Harn, et al.; Expression of Epstein–Barr virus-encoded RNAs as a marker for metastatic undifferentiated nasopharyngeal carcinoma; Cancer, 78 (1996), pp. 24–29
- [12] C.L. Ho, S.H. Lee, L.M. Chen, T.Y. Chao; Epstein–Barr virus early ribonucleic acids as a diagnostic adjunct for relapsed metastatic tumors in patients with cured primary undifferentiated nasopharyngeal carcinoma; Am J Otolaryngol, 21 (2000), pp. 80–84
Document information
Published on 31/08/16
Licence: Other
Share this document
Keywords
claim authorship
Are you one of the authors of this document?